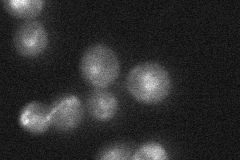
YMR193W

View description
Mitochondrial ribosomal protein of the large subunit
Localization:
Intensity:
Fold change:
Significance:
-
C’ GFP library in SD

nucleolus66.66 -
N' NOP1pr-GFP in SD

mitochondria63.1248 -
N' TEF2pr-mCherry in SD

mitochondria0 -
N' NATIVEpr-GFP in SD
ambiguous32.0705 -
N' TEF2pr-VC and Cyto-VN in SD

#N/A0 -
C’ GFP library in SD+DTT

nucleolus37.150.55Yes -
C’ GFP library in SD+H2O2

nucleolus57.330.85No -
C’ GFP library in Starvation Media

nucleolus49.630.74No -
C’ GFP library on the background of Pup2-DaMP

nucleolus -
C’ GFP library on the background of CCT mutant

nucleolus53.16660.79744No
